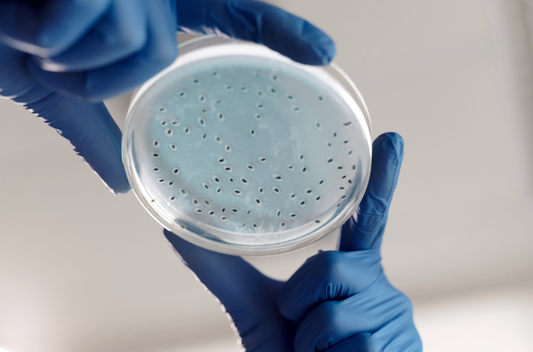
Microbiome insights open new avenues to treat HPV

At CervDefense, our biggest goal is education. We want to educate people with cervixes about their cervixes and about their options. Check out the below, which is a curated list of blogs, articles, and research related to cervical health, reproductive health, and women's health. It’s your body. Educate yourself about it.
Education
Microbiome insights open new avenues to treat HPV
New research that explores microbial flora's role in HPV, indicating potential treatment avenues. Gardnerella-dominant microbiomes correlate with progressive HPV, while elevated interleukin-1β suggests persistent infection. Lactobacillus crispatus, beneficial for vaginal...
Microbiome insights open new avenues to treat HPV
New research that explores microbial flora's role in HPV, indicating potential treatment avenues. Gardnerella-dominant microbiomes correlate with progressive HPV, while elevated interleukin-1β suggests persistent infection. Lactobacillus crispatus, beneficial for vaginal...

NYT: “Half the World Has a Clitoris. Why Don’t ...
In this important piece from the New York Times, it shows that a patient's clitoral anatomy is often overlooked in medical examinations, leading to potential harm and overlooked sexual health...
NYT: “Half the World Has a Clitoris. Why Don’t ...
In this important piece from the New York Times, it shows that a patient's clitoral anatomy is often overlooked in medical examinations, leading to potential harm and overlooked sexual health...

Connecting the Dots: Sexual and Reproductive He...
In this paper from the Population Fund, they discuss how global gender equality and empowerment are widely acknowledged as crucial goals, requiring dedicated efforts in women's and girls' health, freedom...
Connecting the Dots: Sexual and Reproductive He...
In this paper from the Population Fund, they discuss how global gender equality and empowerment are widely acknowledged as crucial goals, requiring dedicated efforts in women's and girls' health, freedom...

Traditional Chinese Medicine: A Viable Alternat...
Myeongae Kang discusses Traditional Chinese Medicine as a viable alternative to loop electrosurgical excision procedures (LEEPs) to treat cervical dysplasia. Historically, Traditional Chinese Medicine has offered a non-surgical alternative for...
Traditional Chinese Medicine: A Viable Alternat...
Myeongae Kang discusses Traditional Chinese Medicine as a viable alternative to loop electrosurgical excision procedures (LEEPs) to treat cervical dysplasia. Historically, Traditional Chinese Medicine has offered a non-surgical alternative for...

Escharotic treatment for cervical intraepitheli...
A 20-year-old woman with recurrent cervical dysplasia, four years post-cervical conization, was diagnosed with CIN II and III. She opted for escharotic treatment twice a week for 5 weeks, alongside oral...
Escharotic treatment for cervical intraepitheli...
A 20-year-old woman with recurrent cervical dysplasia, four years post-cervical conization, was diagnosed with CIN II and III. She opted for escharotic treatment twice a week for 5 weeks, alongside oral...

Cervical Dysplasia
This article by Cindy Micleu, L.Ac discusses cervical dysplasia. An abnormal Pap smear indicates abnormal cells on the cervix, with severity classified based on dysplasia, squamous intraepithelial lesion, or intraepithelial neoplasia.
Cervical Dysplasia
This article by Cindy Micleu, L.Ac discusses cervical dysplasia. An abnormal Pap smear indicates abnormal cells on the cervix, with severity classified based on dysplasia, squamous intraepithelial lesion, or intraepithelial neoplasia.
